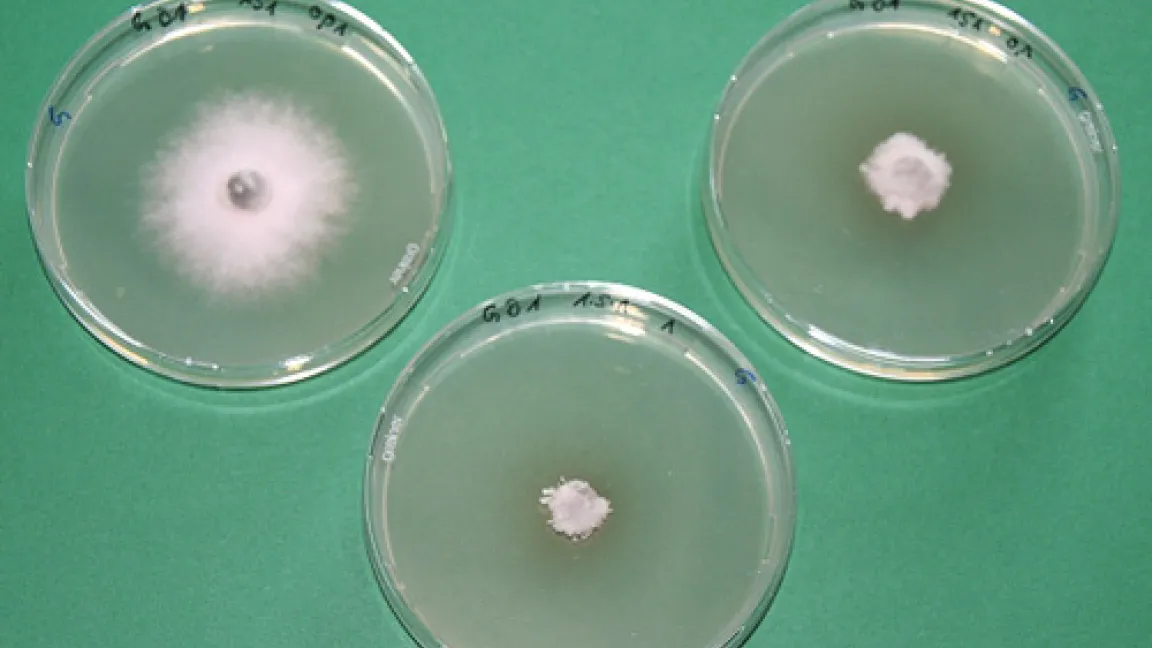

Zunehmend resistent: Die Erreger der Blattdürre
Mutationen im Erbgut machen Getreidepilze gegen Fungizid-Wirkstoffe unempfindlich, die Bekämpfung wird schwieriger
Die Schaderreger der Blattdürre (Septoria tritici) und Drechslera tritici-repentis (DTR) entwickeln immer häufiger Stämme, die gegen Strobilurine resistent sind und zunehmend auch unempfindlicher auf Triazole reagieren. Strobilurine und Triazole sind bislang die wichtigsten Wirkstoffklassen zur Bekämpfung der Blattdürre.Zu dem alarmierenden Ergebnis kam ein dreijähriges europäisches Forschungsprojekt, das „Cereal Disease Control Forum“, das sich mit Getreidekrankheiten befasst. Insgesamt zwölf Institutionen aus Beratung und Wissenschaft aus sieben Ländern waren eingebunden, darunter auch die Biologische Bundesanstalt für Land- und Forstwirtschaft in Braunschweig. Die Arbeiten zu Resistenzen gegenüber Fungiziden wurden von Syngenta Crop Protection gefördert.
Mutationen lösen Resistenz aus
Eine Spontanmutation verursacht die Strobilurin-Resistenz, die sowohl bei Septoria tritici als auch bei DTR auftritt. Ganz neu wurde eine weitere minimale Veränderung im Erbgut von Drechslera tritici-repentis (DTR) entdeckt, die ebenfalls die Wirksamkeit von Strobilurinen herabsetzt. Einige Pilzstämme verfügen bereits über beide Mutationen. Der Resistenzgrad von Septoria gegenüber den Strobilurinen wird auf über 70 Prozent geschätzt. Es ist damit zu rechnen, dass der Blattdürre mit Strobilurinen alleine bald nicht mehr beizukommen ist. Die Studie hat außerdem ergeben, dass der Blattdürre-Erreger auch zunehmend unempfindlicher auf Triazole reagiert.
Einsatz unterschiedlicher Wirkstoffe beugt vor
Für den pilzlichen Schaderreger DTR können die Wissenschaftler die Resistenzverbreitung noch nicht genau abschätzen. Der Nachweis der gleichen Mutationen wie bei Septoria tritici hat jedoch Berichte bestätigt, die bereits darauf hingewiesen haben, dass die Wirksamkeit von Strobilurinen nachlässt. Darüber hinaus fanden die Forscher erste Anzeichen dafür, dass die Empfindlichkeit gegenüber den Triazolen abnimmt. Sie empfehlen, bei der Bekämpfung pilzlicher Schaderreger möglichst mehrere Wirkstoffe mit unterschiedlichen Wirkmechanismen zu verwenden, um der Bildung neuer Resistenzen vorzubeugen. Kontaktwirkstoffen, die auf den Getreideblättern eine spezielle Schutzhülle bilden, kommt bei der Bekämpfung resistenter oder weniger empfindlicher Pilzstämme eine wichtige Rolle zu. Strobilurine sollten im Sinne einer nachhaltigen Bekämpfungsstrategie sehr gezielt eingesetzt werden. Wichtig ist es, die Empfehlungen der Hersteller zu Aufwandmenge, Anzahl der Anwendungen, Anwendungszeitpunkt und Befallsverlauf genau zu berücksichtigen.